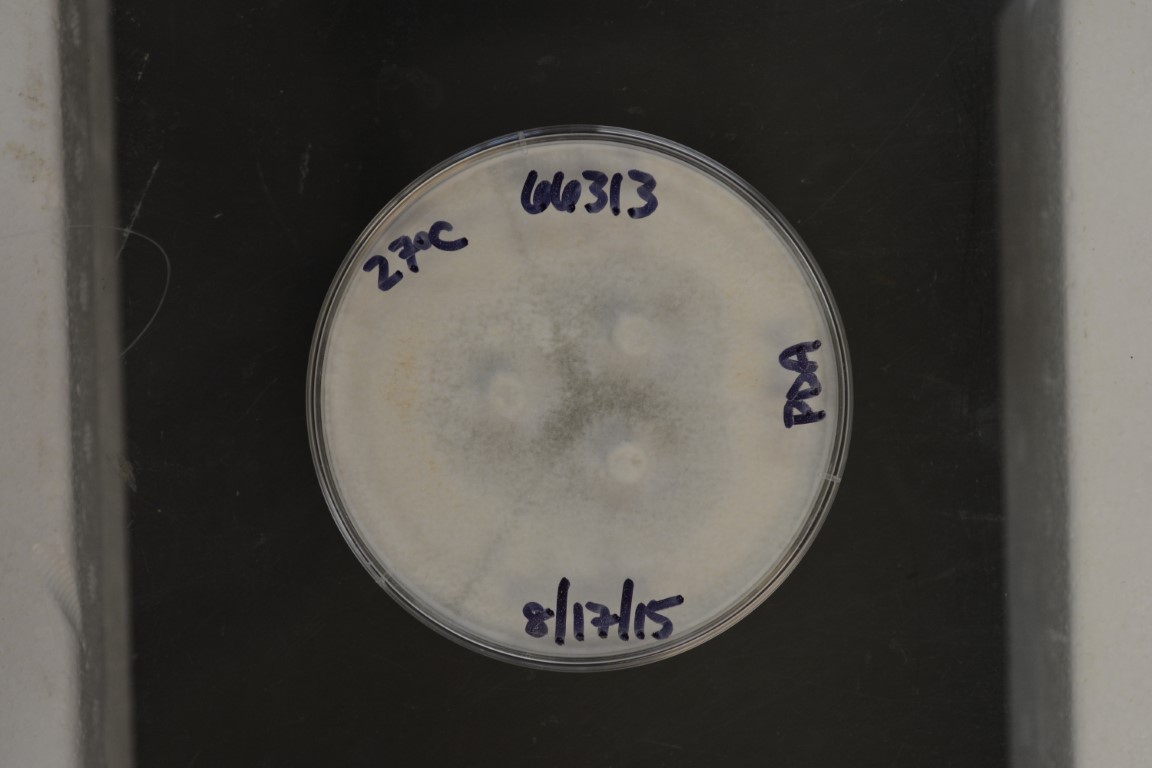

Trametes versicolor
NRRL 66313
Accession numbers in other collections:WC 861
Source:Michael J.Shreve,Pennsylvania State University-->Shanghai Fungi Institute:Culture 1
Substrate location:Shanghai,China
Genetic info:Genbank KR869151
Growth media:Potato Dextrose Agar(number 3)
Optimum growth temperature:27C
Strain images:
NRRL_66313_3.jpg

Comments:Is said to have anti-tumor activity
This strain is a regulated plant pathogen.An APHIS PPQ 526 permit is required for distribution in the United States.For international requests,an importation permit or an official letter from the appropriate government agency declaring that a permit is not required must be provided in advance of shipment.
NRRL66313